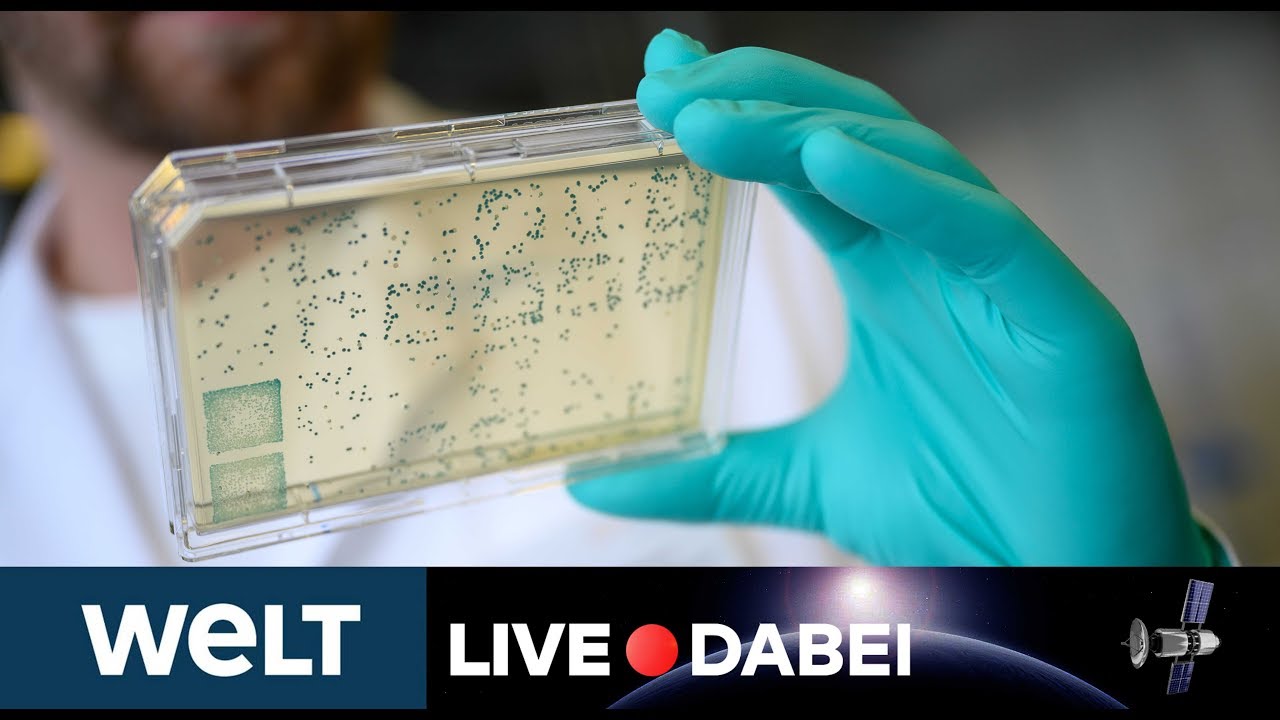

Die Bundesregierung beteiligt sich mit 300 Millionen Euro an der Firma CureVac, die einen Impfstoff gegen das Coronavirus sucht. Das teilte das Wirtschaftsministerium am Montag mit.
Gemeinsam mit Italien, Frankreich und den Niederlanden hat die Bundesrepublik sich rund 400 Millionen Impfdosen gesichert. Schon Ende des Jahres soll es nämlich einen Corona-Impfstoff geben. Die Bundesregierung schätzt die Wahrscheinlichkeit, dass dieser Impfstoff auch funktioniert auf 90 Prozent. Wie hoch die Kosten bei dem Impf-Deal waren, ist bislang nicht bekannt.
#corona #curevac #impfstoff
Der WELT Nachrichten-Livestream
Abonniere den WELT YouTube Channel
Die Top-Nachrichten auf WELT.de
Unsere Reportagen & Dokumentationen
Die Mediathek auf WELT.de
WELT Nachrichtensender auf Instagram
WELT auf Instagram
In eigener Sache: Wegen des hohen Aufkommens unsachlicher und beleidigender Beiträge können wir zurzeit keine Kommentare mehr zulassen.
Danke für Eurer Verständnis – das WELT-Team
Video 2020 erstellt